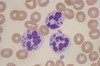

48M with fever, dyspnea and painful blistering lesions. Also loss of eyebrows and swelling of earlobes with diffuse alopecia. Biopsy revealed thrombosis of medium sized arteries with plasma cells and foamy macrophages. Acid Fast Bacilli noted.
What is this diagnosis?
What is the treatment?
*Side effect?

Lucios Phenomenon - necrotic skin lesions in diffuse lepromatous leprosy
treat with rifampin, clofazamine and dapsone as well as steroids and ACG
*clofaz AE: skin pigmentation, abdominal pain, eye irritation
Patient develops asymptomatic elevations of AST/ALT.
Avid sausage-eater from Germany.
Hepatitis E!!
Patient presents 2 months after getting bit by a wild skunk.
Should you provide RIG/Vaccinate?
What is the vaccine series?
YES! Incubation period is up to 90 days.
Rabies Vaccine: Day 0, 3, 7, 14
Diarrhea outbreak among household contacts. Incubation period is 3-7 days.
most likely either norovirus or shigella - most communicable enteric pathogens
salmonella rarely causes secondary spread. Campy, non-cholera vibrios and aeromonas are less likely to have secondary spread.
31M bilateral pneumonia non responsive to augmentin as outpatient.
All cultures negative. Found to have palpable spleen tip and red macules on abdomen.
Recent parrot exposure
Chlamydia psittacia
Rx doxycycline
cosmetic procedure now growing AFB
which are the BAD ones?
which have inherent inducible resistance?
Empiric Treatment?
RGM (m. abscessus, fortuitum or chelonae)
abscessus and chelonae should get surgery “like tumors”
fortuitum and abscessus have erm gene (macrolides)
Some combination of linezolid, doxy, cipro, azithro +/- clofaz if you have it
55F fevers, cytopenias and found to have granulomas in bone marrow 6 months after cardiac bypass surgery
Nosocomial M. Chimaera outbreak from Heater Cooler Units
High mortality 50%
Must remove prosthetic material and then at 1 year of therapy afterward

bicyclist scrapes elbow in muddy pool of water. Develops tenderness/drainage - GNRs
aeromonas - rx with cipro
HIV patient with “worst sore throat of my life” but OP exam is normal
Suspect: Epiglottitis
crab fisherman from chesapeake p/w red painful hand - has progressed over 4 days. Finger joints feel stiff but there is no swelling on exam
erisipelothrix - subacute cellulitis due to inocculation with GP bacillus
can also disseminate - causing rash and endocarditis
23M acute pain and blurred vision in R-eye.
How to treat?

Topical antivirals +/- debridement and systemic antiviral
triflueorothymidine, vidarabine, idoxuridine, acyclovir

ocular pain, redness, increased lacrimation, photophobia, and blurred vision
what SYNDROME is this?
Uveitis/Iritis

fried egg colonies on cell free medium
mycoplasma
Oysters
Vibrio parahaemolyticus
vibrio vulnificus (septicemia and STI)
differences between FMF and TRAPS?
Ethnicity
Pattern of inherentance (recessive - TRAPS is dominant)
TRAPS has myalgias and conjunctivitis
TNF-a in TRAPS, colchicine in FMF
both can be c/b amyloidosis
Painless ulcer with TENDER inguinal adenopathy
LGV (chlamydia L1-3)
Rx with doxy
painLESS ulcer NO adenoapthy
Granuloma Inguinale (Donovanosis/Klebsiella)
Rx with Doxy/Azithro
3 weeks!
TORCH
Toxo, Other, Rubella, CMV, HSV
*Other: Syph, Listeria, VZV, Parvo
Can cause spontaneous abortion, premature birth, IUGR
Hepatitis in a pregnant patient
HSV!
Also think of adenovirus - HSV and adeno can cause fulminant Hep in Preg/Immunosuppressed
Clinically identifical to PCP except PCR is negative?
Toxoplasma Pneumonia
Rare, but Clinically identical to PJP, and would also be prevented by Bactrim ppx
asian with recurrent blisters and aseptic meningitis - Rx?
Colchicine for behcets

roseola (HHV6 “6th disease” - normally a mild febrile/rash illness in children, but can cause complications in IC hosts in adulthood)

roth spot - red lesion with pale center in Bacterial Endocarditis
HHV8 (3 syndromes)
KS
Castleman’s
PEL